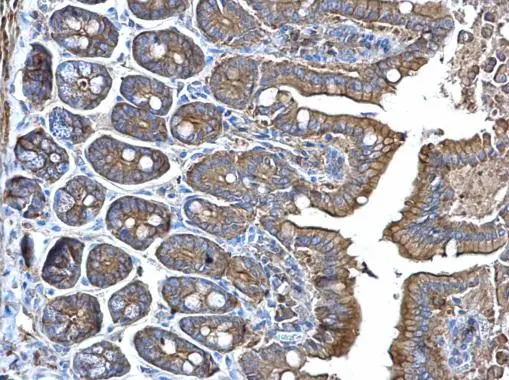
alpha Adducin antibody detects alpha Adducin protein at membrane on mouse intestine by immunohistochemical analysis. Sample: Paraffin-embedded mouse intestine. alpha Adducin antibody (GTX101600) dilution: 1:500. 
 Antigen Retrieval: Trilogy? (EDTA based, pH 8.0) buffer, 15min

alpha Adducin antibody detects alpha Adducin protein on whole-mount zebrafish embryos by immunohistochemical analysis. Sample: Paraformaldehyde-fixed zebrafish embryos. alpha Adducin antibody (GTX101600) dilution: 1:200.
alpha Adducin antibody
GTX101600
ApplicationsImmunoFluorescence, Western Blot, ImmunoCytoChemistry, ImmunoHistoChemistry, ImmunoHistoChemistry Paraffin
Product group Antibodies
ReactivityHuman, Mouse, Zebra Fish
TargetADD1
Overview
- SupplierGeneTex
- Product Namealpha Adducin antibody
- Delivery Days Customer9
- Application Supplier NoteWB: 1:500-1:3000. ICC/IF: 1:100-1:1000. IHC-P: 1:100-1:1000. *Optimal dilutions/concentrations should be determined by the researcher.Not tested in other applications.
- ApplicationsImmunoFluorescence, Western Blot, ImmunoCytoChemistry, ImmunoHistoChemistry, ImmunoHistoChemistry Paraffin
- CertificationResearch Use Only
- ClonalityPolyclonal
- Concentration1.02 mg/ml
- ConjugateUnconjugated
- Gene ID118
- Target nameADD1
- Target descriptionadducin 1
- Target synonymsADDA, alpha-adducin, adducin 1 (alpha), alpha-adducin 1, erythrocyte adducin alpha subunit
- HostRabbit
- IsotypeIgG
- Protein IDP35611
- Protein NameAlpha-adducin
- Scientific DescriptionAdducins are a family of cytoskeleton proteins encoded by three genes (alpha, beta, gamma). Adducin is a heterodimeric protein that consists of related subunits, which are produced from distinct genes but share a similar structure. Alpha- and beta-adducin include a protease-resistant N-terminal region and a protease-sensitive, hydrophilic C-terminal region. Alpha- and gamma-adducins are ubiquitously expressed. In contrast, beta-adducin is expressed at high levels in brain and hematopoietic tissues. Adducin binds with high affinity to Ca(2+)/calmodulin and is a substrate for protein kinases A and C. Alternative splicing results in multiple variants encoding distinct isoforms; however, not all variants have been fully described. [provided by RefSeq]
- ReactivityHuman, Mouse, Zebra Fish
- Storage Instruction-20°C or -80°C,2°C to 8°C
- UNSPSC41116161

![alpha Adducin antibody [N1N2], N-term detects alpha Adducin protein at nucleus on whole-mount zebrafish embryos by immunohistochemical analysis. Sample: Paraformaldehyde-fixed zebrafish embryos. alpha Adducin antibody [N1N2], N-term (GTX113118) dilution: 1:200.](https://www.genetex.com/upload/website/prouct_img/normal/GTX113118/GTX113118_40086_IHC-Wm_Z_22111423_628.webp)